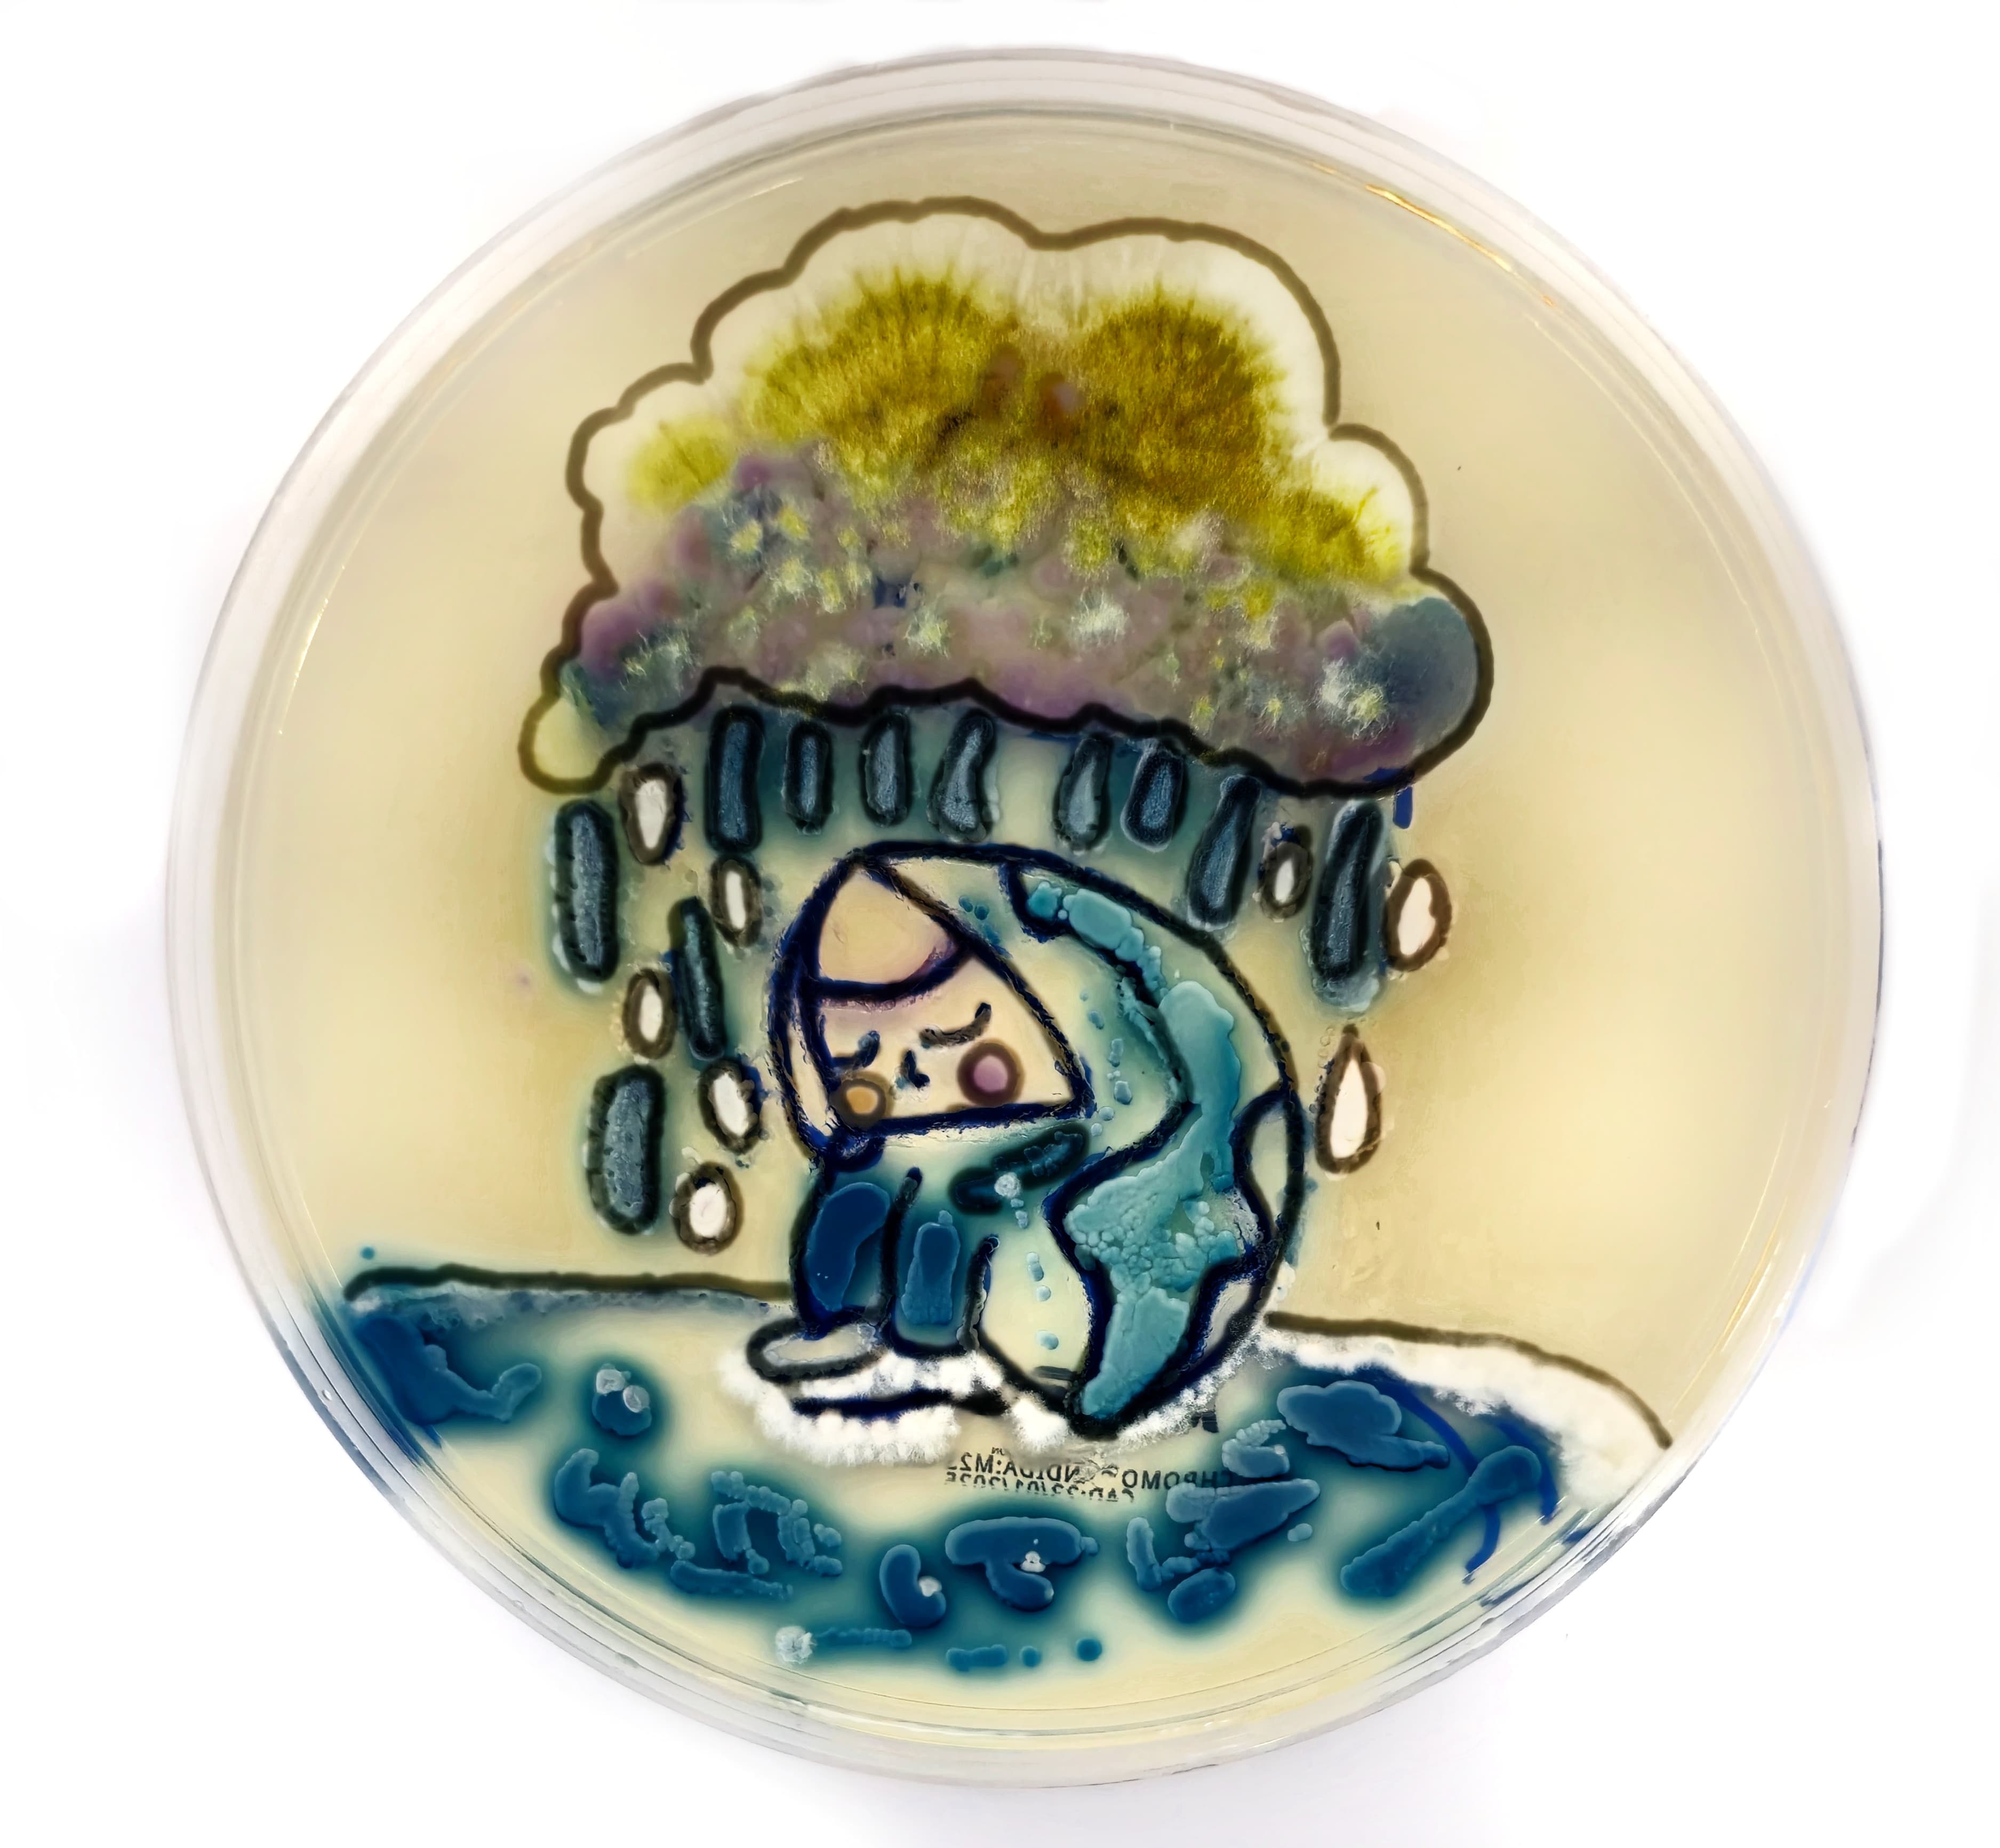

Pathology
Captures
2025
Our annual celebration of #pathart
from clinical professionals worldwide!
Welcome to the 10th edition of The Pathologist image feature! Our stunning annual galleries showcase the creativity of you, the pathology community. This year we were inundated with a plethora of artworks across a variety of mediums: agar plates, poems, cakes, crochet, and paintings galore! Thank you to all of our amazing artists for allowing us to showcase their talents.
Now, take a step into our gallery to see the creativity and joy that “Pathology Captures”.
Interested in getting your #pathart creations into a future edition of The Pathologist? Share your work with us to feature as our next image of the month!
Painting / Drawing
LCIS by Virginia Fernandez, Pathology Resident, Department of Pathology and Laboratory Medicine, University of Miami Health System/Jackson Memorial Hospital, US. This watercolor interpretation of lobular carcinoma in situ (LCIS) transforms microscopic pathology into an artistic expression. The loosely cohesive tumor cells are depicted with delicate brushstrokes, allowing their subtle infiltration to emerge organically on the canvas.
LCIS by Virginia Fernandez, Pathology Resident, Department of Pathology and Laboratory Medicine, University of Miami Health System/Jackson Memorial Hospital, US. This watercolor interpretation of lobular carcinoma in situ (LCIS) transforms microscopic pathology into an artistic expression. The loosely cohesive tumor cells are depicted with delicate brushstrokes, allowing their subtle infiltration to emerge organically on the canvas.
Ameloblastoma by Virginia Fernandez, Pathology Resident, Department of Pathology and Laboratory Medicine, University of Miami Health System/Jackson Memorial Hospital, US. This watercolor piece captures the intricate histology of an ameloblastoma, translating its characteristic palisading basal cells and stellate reticulum into delicate brushstrokes. The fluidity of watercolor mirrors the organic (sometimes cystic) architecture of the tumor, highlighting both its complexity and beauty.
Ameloblastoma by Virginia Fernandez, Pathology Resident, Department of Pathology and Laboratory Medicine, University of Miami Health System/Jackson Memorial Hospital, US. This watercolor piece captures the intricate histology of an ameloblastoma, translating its characteristic palisading basal cells and stellate reticulum into delicate brushstrokes. The fluidity of watercolor mirrors the organic (sometimes cystic) architecture of the tumor, highlighting both its complexity and beauty.
Hyalinizing Trabecular Tumor by Virginia Fernandez, Pathology Resident, Department of Pathology and Laboratory Medicine, University of Miami Health System/Jackson Memorial Hospital, US. This watercolor piece brings the unique histology of a hyalinizing trabecular tumor (HTT) to life, capturing its distinctive trabecular growth pattern and dense hyalinized stroma. The elongated, spindle-shaped tumor cells are delicately rendered, their arrangement forming interwoven ribbons that mimic the architecture seen under the microscope.
Hyalinizing Trabecular Tumor by Virginia Fernandez, Pathology Resident, Department of Pathology and Laboratory Medicine, University of Miami Health System/Jackson Memorial Hospital, US. This watercolor piece brings the unique histology of a hyalinizing trabecular tumor (HTT) to life, capturing its distinctive trabecular growth pattern and dense hyalinized stroma. The elongated, spindle-shaped tumor cells are delicately rendered, their arrangement forming interwoven ribbons that mimic the architecture seen under the microscope.
Cerebellum by Virginia Fernandez, Pathology Resident, Department of Pathology and Laboratory Medicine, University of Miami Health System/Jackson Memorial Hospital, US. This watercolor piece captures the intricate layers of cerebellar histology, transforming neural architecture into a fluid and organic composition.
Cerebellum by Virginia Fernandez, Pathology Resident, Department of Pathology and Laboratory Medicine, University of Miami Health System/Jackson Memorial Hospital, US. This watercolor piece captures the intricate layers of cerebellar histology, transforming neural architecture into a fluid and organic composition.
ACC by Vaishali Masatkar, Dermatologist and 2025 Pathology Match applicant, India. Adenoid cystic carcinoma with a cribriform pattern and perineural invasion.
ACC by Vaishali Masatkar, Dermatologist and 2025 Pathology Match applicant, India. Adenoid cystic carcinoma with a cribriform pattern and perineural invasion.
Hair Follicle Illustration by Vaishali Masatkar, Dermatologist and 2025 Pathology Match applicant, India. Vertical and corresponding transverse sections of an anagen hair follicle.
Hair Follicle Illustration by Vaishali Masatkar, Dermatologist and 2025 Pathology Match applicant, India. Vertical and corresponding transverse sections of an anagen hair follicle.
PathoVanguard by Meredith K. Herman, Pathology Resident, University of Michigan, US. This painting presents an abstract interpretation of a microscope, its intricate components distilled into a series of bold geometric shapes and dynamic forms. At the center, a large circular lens is represented, surrounded by intersecting lines of fiery red and bright yellow that radiate outward – symbolizing the microscope's magnifying power. The body of the microscope is fragmented into angular planes, each painted in blocks of red, blue, and yellow, creating a sense of movement and depth as if the viewer is peering through layers of focus. The brushstrokes are energetic and sweeping, with color blending and breaking in unexpected ways, evoking a sense of scientific exploration and discovery. The primary colors dominate the composition, each contributing to the intensity of the piece – red suggests passion and urgency, yellow evokes clarity and light, and blue offers depth and introspection. The overall effect is a bold, dynamic reflection on the microscopic world through the lens of abstract expressionism.
PathoVanguard by Meredith K. Herman, Pathology Resident, University of Michigan, US. This painting presents an abstract interpretation of a microscope, its intricate components distilled into a series of bold geometric shapes and dynamic forms. At the center, a large circular lens is represented, surrounded by intersecting lines of fiery red and bright yellow that radiate outward – symbolizing the microscope's magnifying power. The body of the microscope is fragmented into angular planes, each painted in blocks of red, blue, and yellow, creating a sense of movement and depth as if the viewer is peering through layers of focus. The brushstrokes are energetic and sweeping, with color blending and breaking in unexpected ways, evoking a sense of scientific exploration and discovery. The primary colors dominate the composition, each contributing to the intensity of the piece – red suggests passion and urgency, yellow evokes clarity and light, and blue offers depth and introspection. The overall effect is a bold, dynamic reflection on the microscopic world through the lens of abstract expressionism.
Adenoma by Meredith K. Herman, Pathology Resident, University of Michigan, US. This watercolor painting of a colon adenoma, rendered in the classical hues of hematoxylin and eosin (H&E) staining, takes on a strikingly elegant – yet scientific – aesthetic. The adenoma itself is depicted in shades of deep purple and blue, a rich, royal hue that reflects the intense nuclear staining of hematoxylin. These cool tones emphasize the highly cellular nature of the adenoma, with elongated and irregular glandular structures outlined in bold strokes, suggesting hyperplastic cell growth. The staining of the nuclei is intricate with darker purple areas interspersed with lighter lavenders, illustrating the varying degrees of cellular activity and division.
Adenoma by Meredith K. Herman, Pathology Resident, University of Michigan, US. This watercolor painting of a colon adenoma, rendered in the classical hues of hematoxylin and eosin (H&E) staining, takes on a strikingly elegant – yet scientific – aesthetic. The adenoma itself is depicted in shades of deep purple and blue, a rich, royal hue that reflects the intense nuclear staining of hematoxylin. These cool tones emphasize the highly cellular nature of the adenoma, with elongated and irregular glandular structures outlined in bold strokes, suggesting hyperplastic cell growth. The staining of the nuclei is intricate with darker purple areas interspersed with lighter lavenders, illustrating the varying degrees of cellular activity and division.
Small Intestine by Meredith K. Herman, Pathology Resident, University of Michigan, US. This watercolor painting of the small intestine, using hematoxylin and eosin (H&E) colors, captures its intricate histology. The villi are depicted in rich purples and blues, representing hematoxylin-stained nuclei, while the cytoplasm of enterocytes flows in soft pinks and reds. The deeper layers, including the lamina propria, are rendered in translucent pinks, highlighting capillaries and immune cells. Darker purple hints in the crypts of Lieberkühn illustrate cell division. The fluidity of watercolor reflects the dynamic, regenerative processes of the small intestine, with a balance of structure and function, portraying the vital role of nutrient absorption and cellular renewal.
Small Intestine by Meredith K. Herman, Pathology Resident, University of Michigan, US. This watercolor painting of the small intestine, using hematoxylin and eosin (H&E) colors, captures its intricate histology. The villi are depicted in rich purples and blues, representing hematoxylin-stained nuclei, while the cytoplasm of enterocytes flows in soft pinks and reds. The deeper layers, including the lamina propria, are rendered in translucent pinks, highlighting capillaries and immune cells. Darker purple hints in the crypts of Lieberkühn illustrate cell division. The fluidity of watercolor reflects the dynamic, regenerative processes of the small intestine, with a balance of structure and function, portraying the vital role of nutrient absorption and cellular renewal.
Basal Cell Carcinoma on an Eyelid by Kait Grimes, Second year medical student at Carver College of Medicine, Iowa, US. The size and details made this really fun to paint.
Basal Cell Carcinoma on an Eyelid by Kait Grimes, Second year medical student at Carver College of Medicine, Iowa, US. The size and details made this really fun to paint.
The Retina by Kait Grimes, Second year medical student at Carver College of Medicine, Iowa, US. Possibly my favorite, given one of the specialties I'm interested in is ophthalmology.
The Retina by Kait Grimes, Second year medical student at Carver College of Medicine, Iowa, US. Possibly my favorite, given one of the specialties I'm interested in is ophthalmology.
The Crypts of Lieberkuhn by Kait Grimes, Second year medical student at Carver College of Medicine, Iowa, US. Small intestine.
The Crypts of Lieberkuhn by Kait Grimes, Second year medical student at Carver College of Medicine, Iowa, US. Small intestine.
Epithelial Dysplasia by Preetha Selvan, Assistant Professor, Department of Oral and Maxillofacial Pathology, Ragas Dental College, Chennai, TamilNadu, India. This illustration visually represents the progressive histopathological changes from normal mucosa to invasive carcinoma. It highlights key cytological alterations, including nuclear size variation, abnormal mitotic figures, and hyperchromatic nuclei – making it an effective educational tool.
Epithelial Dysplasia by Preetha Selvan, Assistant Professor, Department of Oral and Maxillofacial Pathology, Ragas Dental College, Chennai, TamilNadu, India. This illustration visually represents the progressive histopathological changes from normal mucosa to invasive carcinoma. It highlights key cytological alterations, including nuclear size variation, abnormal mitotic figures, and hyperchromatic nuclei – making it an effective educational tool.
Carcinogenesis by Preetha Selvan, Assistant Professor, Department of Oral and Maxillofacial Pathology, Ragas Dental College, Chennai, TamilNadu, India. This illustration effectively simplifies the complex process of cancer development using symbolic representations. It depicts carcinogenic agents triggering genetic mutations, leading to hyperplasia, dysplasia, and ultimately carcinoma. The immune system's role in tumor progression is also highlighted, making the concept more accessible for learners.
Carcinogenesis by Preetha Selvan, Assistant Professor, Department of Oral and Maxillofacial Pathology, Ragas Dental College, Chennai, TamilNadu, India. This illustration effectively simplifies the complex process of cancer development using symbolic representations. It depicts carcinogenic agents triggering genetic mutations, leading to hyperplasia, dysplasia, and ultimately carcinoma. The immune system's role in tumor progression is also highlighted, making the concept more accessible for learners.
Agar Art
Boxing Bacteria by Selma Habibovic, Specialist in Medical Microbiology, Department of Microbiology, Public Health Institute Novi Pazar, Serbia. Antimicrobial resistance (AMR) is a critical global health challenge causing millions of deaths annually – and numbers are steadily increasing. I depict this challenge through the metaphor of a boxing match between bacteria and antibiotics. The canvas is HiCromeUTI agar and the brushes are sterile inoculating loops. The microorganisms used in the artwork include Escherichia coli, Klebseilla pneumoniae, Proteus mirabilis, Enterococcus faecalis, and Candida albicans. Climate change plays a significant role in escalating bacterial antibiotic resistance, while migration and overpopulation exacerbate its spread. Addressing this issue requires a multidisciplinary approach and collective efforts to tackle climate change’s impact on AMR.
Boxing Bacteria by Selma Habibovic, Specialist in Medical Microbiology, Department of Microbiology, Public Health Institute Novi Pazar, Serbia. Antimicrobial resistance (AMR) is a critical global health challenge causing millions of deaths annually – and numbers are steadily increasing. I depict this challenge through the metaphor of a boxing match between bacteria and antibiotics. The canvas is HiCromeUTI agar and the brushes are sterile inoculating loops. The microorganisms used in the artwork include Escherichia coli, Klebseilla pneumoniae, Proteus mirabilis, Enterococcus faecalis, and Candida albicans. Climate change plays a significant role in escalating bacterial antibiotic resistance, while migration and overpopulation exacerbate its spread. Addressing this issue requires a multidisciplinary approach and collective efforts to tackle climate change’s impact on AMR.
One Health Bacteria by Selma Habibovic, Specialist in Medical Microbiology, Department of Microbiology, Public Health Institute Novi Pazar, Serbia. One Health concept (una sola salud) presented through bacteria, which are an integral part of humans, animals, and the environment. Life without them would be unimaginable. The canvas is HiCrome UTI agar. Microorganisms used for drawing: E. coli, S. saprophyticus, Pseudomonas aeruginose, and Klebsiella penumoniae.
One Health Bacteria by Selma Habibovic, Specialist in Medical Microbiology, Department of Microbiology, Public Health Institute Novi Pazar, Serbia. One Health concept (una sola salud) presented through bacteria, which are an integral part of humans, animals, and the environment. Life without them would be unimaginable. The canvas is HiCrome UTI agar. Microorganisms used for drawing: E. coli, S. saprophyticus, Pseudomonas aeruginose, and Klebsiella penumoniae.
Sleeping Beauty by Cristina-Miriam Blaga, Loius Țurcanu Emergency Clinical Hospital for Children, Romania. Sleeping Beauty, frozen for eternity in her icy tomb, stirs to life with the sun's tender, warming kiss. With global warming, we will encounter infections that are unfamiliar to us – frightening in their impact yet strangely fascinating in their complexity. Created with Pseudomonas aeruginosa, S. aureus, Micrococcus spp, Candida spp, Enterococcus faecalis, and Enterococcus faecium bacteria.
Sleeping Beauty by Cristina-Miriam Blaga, Loius Țurcanu Emergency Clinical Hospital for Children, Romania. Sleeping Beauty, frozen for eternity in her icy tomb, stirs to life with the sun's tender, warming kiss. With global warming, we will encounter infections that are unfamiliar to us – frightening in their impact yet strangely fascinating in their complexity. Created with Pseudomonas aeruginosa, S. aureus, Micrococcus spp, Candida spp, Enterococcus faecalis, and Enterococcus faecium bacteria.
Plague Doctor by Andres Daniel Cevallos Cevallos, ReactivLab, Quito, Ecuador. The drawing of Dr Plague is made with Klebsiella pneumoniae bacteria that gives a dark metallic blue color to the agar-agar. The iconic medical mask against plague, a symbol of protection against infectious diseases in the past, reminds us how humanity has sought to defend itself against epidemics. This historical parallel underscores the urgency of addressing the effects of global warming on public health, integrating scientific knowledge and collective action to prevent future health crises.
Plague Doctor by Andres Daniel Cevallos Cevallos, ReactivLab, Quito, Ecuador. The drawing of Dr Plague is made with Klebsiella pneumoniae bacteria that gives a dark metallic blue color to the agar-agar. The iconic medical mask against plague, a symbol of protection against infectious diseases in the past, reminds us how humanity has sought to defend itself against epidemics. This historical parallel underscores the urgency of addressing the effects of global warming on public health, integrating scientific knowledge and collective action to prevent future health crises.
Acid Tears by Maritza Arevalo Luzuriaga, Clinical Pathologist. Created using various Candida strains, including C. krusei, C. albicans, and C. tropicalis, as well as filamentous fungi such as Aspergillus niger and Penicillium chrysogenum.
Acid Tears by Maritza Arevalo Luzuriaga, Clinical Pathologist. Created using various Candida strains, including C. krusei, C. albicans, and C. tropicalis, as well as filamentous fungi such as Aspergillus niger and Penicillium chrysogenum.
Slide Images
Evita Sadimin, Associate Professor and Division Chief at City of Hope National Medical Center, Duarte, California, US. Low grade non-invasive papillary urothelial carcinoma occluding the ureter.
Evita Sadimin, Associate Professor and Division Chief at City of Hope National Medical Center, Duarte, California, US. Low grade non-invasive papillary urothelial carcinoma occluding the ureter.
Smiling Trichoadenoma by Gamal Dawood, Professor of Pathology at Al-Azhar Faculty of Medicine, Cairo, Egypt. Trichoadenoma is a rare, benign skin tumor that originates from the hair follicle structure. It typically presents as a solitary, asymptomatic, skin-colored, or slightly erythematous papule or nodule – often on the face or trunk. Pathologically, it consists of numerous small, keratin-filled cysts or duct-like structures resembling hair follicles. The cysts are lined by squamous epithelium, often with a granular layer, mimicking the infundibular portion of hair follicles. Surrounding stroma is usually fibrotic or sclerotic. The tumor cells are bland and lack significant atypia or mitotic activity, consistent with its benign nature. There is no evidence of invasive growth or malignant transformation.
Smiling Trichoadenoma by Gamal Dawood, Professor of Pathology at Al-Azhar Faculty of Medicine, Cairo, Egypt. Trichoadenoma is a rare, benign skin tumor that originates from the hair follicle structure. It typically presents as a solitary, asymptomatic, skin-colored, or slightly erythematous papule or nodule – often on the face or trunk. Pathologically, it consists of numerous small, keratin-filled cysts or duct-like structures resembling hair follicles. The cysts are lined by squamous epithelium, often with a granular layer, mimicking the infundibular portion of hair follicles. Surrounding stroma is usually fibrotic or sclerotic. The tumor cells are bland and lack significant atypia or mitotic activity, consistent with its benign nature. There is no evidence of invasive growth or malignant transformation.
Edges by Amy Lark, Staff Pathologist, Durham Veterans Medical Center, North Carolina, US. My images focus on a genre of abstract histology.
Edges by Amy Lark, Staff Pathologist, Durham Veterans Medical Center, North Carolina, US. My images focus on a genre of abstract histology.
Crystal Bouquet by Amy Lark, Staff Pathologist, Durham Veterans Medical Center, North Carolina, US. My images focus on a genre of abstract histology.
Crystal Bouquet by Amy Lark, Staff Pathologist, Durham Veterans Medical Center, North Carolina, US. My images focus on a genre of abstract histology.
Portal by Amy Lark, Staff Pathologist, Durham Veterans Medical Center, North Carolina, US. My images focus on a genre of abstract histology.
Portal by Amy Lark, Staff Pathologist, Durham Veterans Medical Center, North Carolina, US. My images focus on a genre of abstract histology.
Cytological Donut by Gabriel Arismendi Morillo, Pathologist, Department of Medicine, University of Deusto, Spain.
Cytological Donut by Gabriel Arismendi Morillo, Pathologist, Department of Medicine, University of Deusto, Spain.
Cosmic Explosion by Gabriel Arismendi Morillo, Pathologist, Department of Medicine, University of Deusto, Spain. Image shows Rhinopharingeal Mucormycosis.
Cosmic Explosion by Gabriel Arismendi Morillo, Pathologist, Department of Medicine, University of Deusto, Spain. Image shows Rhinopharingeal Mucormycosis.
Amazed by Gabriel Arismendi Morillo, Pathologist, Department of Medicine, University of Deusto, Spain. Neoplastic pleural effusion.
Amazed by Gabriel Arismendi Morillo, Pathologist, Department of Medicine, University of Deusto, Spain. Neoplastic pleural effusion.
Diagnosis: Hypergenius by Scopio Labs. This is an image of a peripheral blood smear sample scanned with a high-resolution imaging device. These scans reveal cellular details that often surprise us – including silhouettes of Albert Einstein!
Diagnosis: Hypergenius by Scopio Labs. This is an image of a peripheral blood smear sample scanned with a high-resolution imaging device. These scans reveal cellular details that often surprise us – including silhouettes of Albert Einstein!
The Breath That Never Came by Kateryna Gurska, Pathology Resident, Amosov National Institute of Cardiovascular Surgery, Kyiv, Ukraine. Male 51 yo, autopsy, signs of COPD: epithelium of bronchial glands and bronchi's walls is thickened, presence of small lymphocytes. A beautiful picture of horrible disease.
The Breath That Never Came by Kateryna Gurska, Pathology Resident, Amosov National Institute of Cardiovascular Surgery, Kyiv, Ukraine. Male 51 yo, autopsy, signs of COPD: epithelium of bronchial glands and bronchi's walls is thickened, presence of small lymphocytes. A beautiful picture of horrible disease.
End-Stage, Endless Love by Kateryna Gurska, Pathology Resident, Amosov National Institute of Cardiovascular Surgery, Kyiv, Ukraine. A heart captured in a kidney with CKD – love your kidneys and they will maintain your life.
End-Stage, Endless Love by Kateryna Gurska, Pathology Resident, Amosov National Institute of Cardiovascular Surgery, Kyiv, Ukraine. A heart captured in a kidney with CKD – love your kidneys and they will maintain your life.
Minor Glands, Major Love by Kateryna Gurska, Pathology Resident, Amosov National Institute of Cardiovascular Surgery, Kyiv, Ukraine. Heart captured in minor salivary glands.
Minor Glands, Major Love by Kateryna Gurska, Pathology Resident, Amosov National Institute of Cardiovascular Surgery, Kyiv, Ukraine. Heart captured in minor salivary glands.
Hodgkin Lymphoma, Reed- Sternberg cell by Zahra Sarrafan Chaharsoughi, Resident Physician, Department of Pathology, The University of Texas Medical Branch, US, and Fnu Aakash, Assistant Professor, Hematopathology Director, Department of Pathology, The University of Texas Medical Branch, US.
Hodgkin Lymphoma, Reed- Sternberg cell by Zahra Sarrafan Chaharsoughi, Resident Physician, Department of Pathology, The University of Texas Medical Branch, US, and Fnu Aakash, Assistant Professor, Hematopathology Director, Department of Pathology, The University of Texas Medical Branch, US.
Mixed Media
The Broken Globe by Natasza Hain-Saunders, Associate Research Fellow at Edith Cowan University Riley Research Laboratory, Secretary at West Coast Microbiome Network, and Committee Member at WA Branch of Australia Society of Microbiology (ASM), Perth, Australia. This cake was inspired by the ongoing challenge for many communities impacted by the evolving relationship between climate change and vector-borne disease. It depicts a broken and melting snow globe causing chaos- Breaking the traditional geographical barriers of the Aedes aegypti and Anopheles mosquito, and bringing with it the spread of malaria and dengue to previously unaffected regions. Made from a combination of fruit cake, fondant and melted sugar, the entire sculpture is edible.
The Broken Globe by Natasza Hain-Saunders, Associate Research Fellow at Edith Cowan University Riley Research Laboratory, Secretary at West Coast Microbiome Network, and Committee Member at WA Branch of Australia Society of Microbiology (ASM), Perth, Australia. This cake was inspired by the ongoing challenge for many communities impacted by the evolving relationship between climate change and vector-borne disease. It depicts a broken and melting snow globe causing chaos- Breaking the traditional geographical barriers of the Aedes aegypti and Anopheles mosquito, and bringing with it the spread of malaria and dengue to previously unaffected regions. Made from a combination of fruit cake, fondant and melted sugar, the entire sculpture is edible.
Eren Ozturk, Ankara University, Faculty of Medicine, Infectious Disease and Clinical Microbiology Department, Turkey. My acrostic poem explores the profound impact of climate change by intertwining scientific insight with emotional resonance. Each poem aims to inspire awareness and action, drawing from personal observations and the urgency of global environmental crises. Through this creative form, I hope to foster a deeper connection between humanity and the fragile ecosystems we must protect.
Eren Ozturk, Ankara University, Faculty of Medicine, Infectious Disease and Clinical Microbiology Department, Turkey. My acrostic poem explores the profound impact of climate change by intertwining scientific insight with emotional resonance. Each poem aims to inspire awareness and action, drawing from personal observations and the urgency of global environmental crises. Through this creative form, I hope to foster a deeper connection between humanity and the fragile ecosystems we must protect.
Climate Can Change but a Good Microbiology Teacher Never Will by Nechita Madalina, Clinical Microbiologist, Târgu Mures County Emergency Clinical Hospital, România. This image was made with eco-friendly materials, including wood and wool. It represents a unique moment in the life of each microbiology teacher who passionately shares his knowledge with his disciple. I believe that every young microbiologist is the result of the passion and dedication of his teacher who was a model and a good example to follow in choosing this career.
Climate Can Change but a Good Microbiology Teacher Never Will by Nechita Madalina, Clinical Microbiologist, Târgu Mures County Emergency Clinical Hospital, România. This image was made with eco-friendly materials, including wood and wool. It represents a unique moment in the life of each microbiology teacher who passionately shares his knowledge with his disciple. I believe that every young microbiologist is the result of the passion and dedication of his teacher who was a model and a good example to follow in choosing this career.
The Continuous Fight by Nechita Madalina, Clinical Microbiologist, Târgu Mures County Emergency Clinical Hospital, România. This badge represents the harsh reality of our days – the continuous fight of multidrug-resistant bacteria with antibiotics. In the current conditions in which the consumption of antibiotics is increased in most countries, the future does not look very good. Bacteria can create new defense mechanisms that the human species will no longer be able to stop. We are all witnessing an unseen war. Will the human species or bacterial species emerge victorious?
The Continuous Fight by Nechita Madalina, Clinical Microbiologist, Târgu Mures County Emergency Clinical Hospital, România. This badge represents the harsh reality of our days – the continuous fight of multidrug-resistant bacteria with antibiotics. In the current conditions in which the consumption of antibiotics is increased in most countries, the future does not look very good. Bacteria can create new defense mechanisms that the human species will no longer be able to stop. We are all witnessing an unseen war. Will the human species or bacterial species emerge victorious?
In the Aftermath: Facing the Mud of Change by Galadriel Pellejero-Sagastizabal, Infectious Diseases Fellow Physician-Scientist at Hospital Clínico Universitario Lozano Blesa, Zaragoza, Spain. This piece is a tribute to a pivotal moment during the devastating DANA floods in Valencia, Spain (2024). It serves as an urgent warning of how extreme weather events are increasingly overwhelming our healthcare systems. What makes this moment significant is how infectious disease specialists, despite lacking official recognition in Spain, are working alongside other healthcare professionals – demonstrating how the crisis demands collaboration across medical disciplines. Through this work, I hope to inspire action for greater investment in preparedness and support for those on the frontlines of both disaster and recovery. This is not just destruction – it's a call for resilience in an uncertain future.
In the Aftermath: Facing the Mud of Change by Galadriel Pellejero-Sagastizabal, Infectious Diseases Fellow Physician-Scientist at Hospital Clínico Universitario Lozano Blesa, Zaragoza, Spain. This piece is a tribute to a pivotal moment during the devastating DANA floods in Valencia, Spain (2024). It serves as an urgent warning of how extreme weather events are increasingly overwhelming our healthcare systems. What makes this moment significant is how infectious disease specialists, despite lacking official recognition in Spain, are working alongside other healthcare professionals – demonstrating how the crisis demands collaboration across medical disciplines. Through this work, I hope to inspire action for greater investment in preparedness and support for those on the frontlines of both disaster and recovery. This is not just destruction – it's a call for resilience in an uncertain future.
Bacterial Love by Andre Valencio Siqueira, PhD Candidate, Universidade Federal de São Paulo (Unifesp), São Paulo, Brazil. This poem blends science and emotion to tell the story of a microbiologist and their love, which grows like a living organism until it is considered a true infection. Drawing inspiration from poets who have explored the social impact of love and its consequences, the poem transforms emotions into signs and symptoms, using microbiology as a metaphor for the development of passion. Through scientific terms, it invites us to see love as something that spreads, resists, and adapts – just like microscopic life itself.
Bacterial Love by Andre Valencio Siqueira, PhD Candidate, Universidade Federal de São Paulo (Unifesp), São Paulo, Brazil. This poem blends science and emotion to tell the story of a microbiologist and their love, which grows like a living organism until it is considered a true infection. Drawing inspiration from poets who have explored the social impact of love and its consequences, the poem transforms emotions into signs and symptoms, using microbiology as a metaphor for the development of passion. Through scientific terms, it invites us to see love as something that spreads, resists, and adapts – just like microscopic life itself.
Microscopic Colitis: A Path to Answers by Kaitlyn Niznik, 2025 CCYAN Fellow and Art Teacher, New York, US. Diagnosed with Microscopic Colitis, I use my art to learn more about the colon and the breakdown of the disease’s pathology. This piece represents my ongoing medical journey. I hope that through my work, I can spread awareness and encourage self-advocacy in other patients living with invisible illnesses. This digital painting was created in Photoshop.
Microscopic Colitis: A Path to Answers by Kaitlyn Niznik, 2025 CCYAN Fellow and Art Teacher, New York, US. Diagnosed with Microscopic Colitis, I use my art to learn more about the colon and the breakdown of the disease’s pathology. This piece represents my ongoing medical journey. I hope that through my work, I can spread awareness and encourage self-advocacy in other patients living with invisible illnesses. This digital painting was created in Photoshop.
Oligodendroglioma Crochet by Clare Hartman, Third Year Medical Student, University of South Florida Morsani College of Medicine, US. My wall hanging crochet Oligodendroglioma was made out of 11 hexagons with purple and white yarn to mimic the fried egg appearance of the cells. The purple nuclei were all created differently to showcase nuclear atypia and the hexagons are held together with pink wire to mimic the chicken wire feature.
Oligodendroglioma Crochet by Clare Hartman, Third Year Medical Student, University of South Florida Morsani College of Medicine, US. My wall hanging crochet Oligodendroglioma was made out of 11 hexagons with purple and white yarn to mimic the fried egg appearance of the cells. The purple nuclei were all created differently to showcase nuclear atypia and the hexagons are held together with pink wire to mimic the chicken wire feature.
Head Study by Sara Lowe, Holistic and Clinical Practitioner at Sara Lowe Therapies, and Clinical Science Student at Cambridge University, UK. I created this drawing when I was around 13 years old and I think this is wonderful at showcasing how much the human form has inspired me – both in my art and my scientific career. Here, you can see my interest in the intricacies of the human form, involvement for expression and movement. Frontalis muscle, Orbicularis oculi, the depressor, and masseter muscle.
Head Study by Sara Lowe, Holistic and Clinical Practitioner at Sara Lowe Therapies, and Clinical Science Student at Cambridge University, UK. I created this drawing when I was around 13 years old and I think this is wonderful at showcasing how much the human form has inspired me – both in my art and my scientific career. Here, you can see my interest in the intricacies of the human form, involvement for expression and movement. Frontalis muscle, Orbicularis oculi, the depressor, and masseter muscle.
Purity by Sara Lowe, Holistic and Clinical Practitioner at Sara Lowe Therapies, and Clinical Science Student at Cambridge University, UK. Clay study of the human form to convey the essence and presence of the human figure.
Purity by Sara Lowe, Holistic and Clinical Practitioner at Sara Lowe Therapies, and Clinical Science Student at Cambridge University, UK. Clay study of the human form to convey the essence and presence of the human figure.
Exploration of Human Pathology by Sara Lowe, Holistic and Clinical Practitioner at Sara Lowe Therapies, and Clinical Science Student at Cambridge University, UK. Created in 2005 in pencil on acid free paper. Here, the human figure is the focal point, emphasising how it reflects the muscular form.
Exploration of Human Pathology by Sara Lowe, Holistic and Clinical Practitioner at Sara Lowe Therapies, and Clinical Science Student at Cambridge University, UK. Created in 2005 in pencil on acid free paper. Here, the human figure is the focal point, emphasising how it reflects the muscular form.
Soul Window by Caddie Dy Laberiano Fernández, Cytopathologist, Sociedad Latinoamericana de Citopatología. In reflection of Women's Month in March, I wanted to express what is in our souls as women in pathology. We are shaped by our experiences, and as professionals, we must diligently study numerous pathology books, images, and slides in order to save lives. In this image, I represent the thoughts and feelings that occupy our minds while we evaluate the slides.
Soul Window by Caddie Dy Laberiano Fernández, Cytopathologist, Sociedad Latinoamericana de Citopatología. In reflection of Women's Month in March, I wanted to express what is in our souls as women in pathology. We are shaped by our experiences, and as professionals, we must diligently study numerous pathology books, images, and slides in order to save lives. In this image, I represent the thoughts and feelings that occupy our minds while we evaluate the slides.